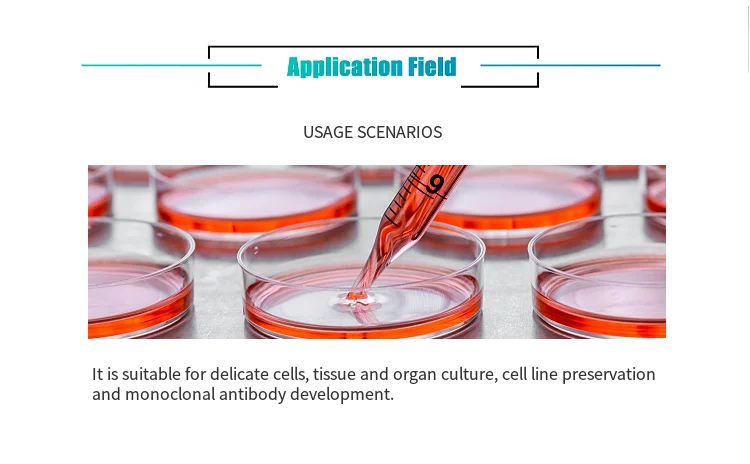

Share on (1600979867165):

Item No. | PBS001 | PBS002 | PBSP001 | PBSP002 |
Item Name | Phosphate Buffered Saline | Phosphate Buffered Saline | Phosphate Buffered Saline | Phosphate Buffered Saline |
Blood Source | China | China | China | China |
Application | Cell Culture | Cell Culture | Cell Culture | Cell Culture |
Warranty | 1Years | 1Years | 1Years | 1Years |




New products from manufacturers at wholesale prices